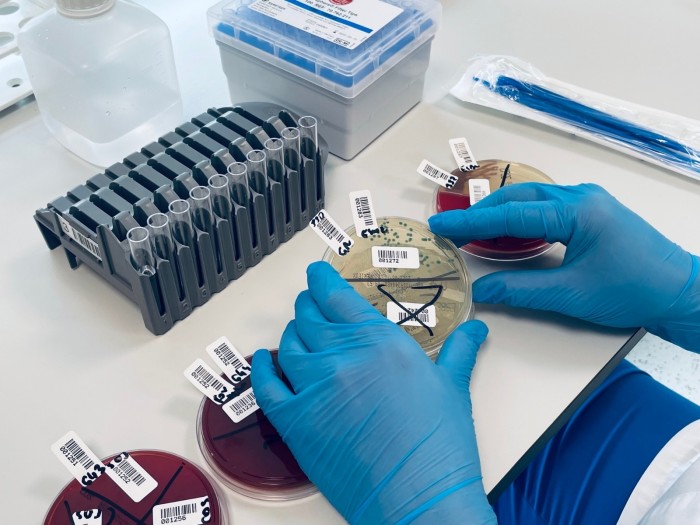
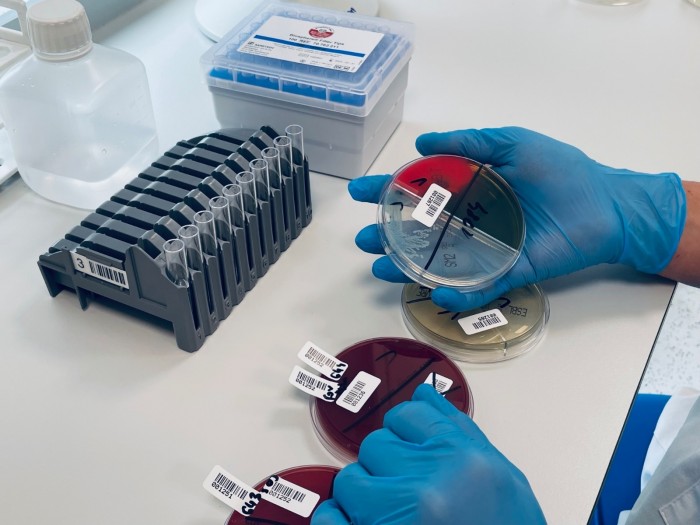

Kontakt do laboratorium:
| tel. 61 222 8 211 | - rejestracja ambulatoryjna |
| tel. 61 222 8 230 | - rejestracja szpitalna |
| tel. 61 222 8 111 | - pracownia główna |
| tel. 61 222 8 276 | - pracownia mikrobiologii |
| tel. 61 222 8 161 | - pracownia serologii transfuzjologicznej |
| tel. 61 222 8 260 | - kierownik |
- 7.00 – 14.30 (od poniedziałku do piątku)
- 7.00 – 13.00 (soboty)
Nasza dewiza to:
- rzetelność
- odpowiedzialność
- dokładność
- nowoczesny sprzęt
- troska o pacjenta
Priorytetem dla Naszego laboratorium jest uzyskanie wysokiej jakości usług, satysfakcjonujących lekarzy i pacjentów. Spełnianie indywidualnych potrzeb każdego pacjenta, przestrzeganie jego praw i poszanowanie osobistej godności, jest dla nas niezmiernie ważne.
Dbając o zagwarantowanie Państwu usług na jak najwyższym poziomie dbamy o wszelkie procesy związane z próbką od momentu pobrania do wydania wyniku. Krew pobierana jest przy pomocy systemu zamkniętego, który nie tylko pozwala pobrać materiał do licznych badań przy jednym ukłuciu, ale także dba o bezpieczeństwo zarówno pacjenta jak i personelu. Badania wykonujemy korzystając z wysokiej klasy analizatorów. Ich praca nadzorowana jest przez doświadczony personel diagnostyczny, który nieustannie podnosi swoje umiejętności. Oferowane przez nas badania podlegają kontroli wewnątrzlaboratoryjnej oraz sprawdzianom zewnątrzlaboratoryjnym. Wszelkie procesy w naszej placówce podlegają standardom zarządzania systemem jakości ISO 9001
Staranność i jakość wykonywania naszych badań pozwala uzyskiwać wyniki wiarygodne i godne zaufania.
Dążąc za rozwojem medycyny nieustannie wzbogacamy swoją ofertę o specjalistyczne badania. Wykonujemy badania z zakresu:
- Biochemii,
- Analityki ogólnej
- Serologii transfuzjologicznej
- Immunodiagnostyki
- hormony tarczycy, hormony płciowe,
- markery nowotworowe,
- choroby zakaźne,
- markery kardiologiczne,
- monitorowanie cukrzycy,
- markery stanu zapalnego,
- diagnostyka anemii
- alergologia (IgE specyficzne – alergeny wziewne i pokarmowe)
- diagnostyka wirusa SARS-CoV-2– przeciwciała SARS-CoV-2 IgG met. ilościową i jakościową, testy antygenowe, testy RT-PCR
Pracownia Mikrobiologii
Diagnostyka mikrobiologiczna ma na celu identyfikację drobnoustrojów chorobotwórczych w materiale klinicznym oraz oznaczenie ich wrażliwości na antybiotyki. Do stosowanych w Pracowni Mikrobiologii metod identyfikacji należą testy manualne oraz automatyczne, natomiast do oznaczania wrażliwości na leki stosujemy metodę dyfuzyjno-krążkową oraz metodę rozcieńczeniową przy użyciu aparatów automatycznych. Wśród wykonywanych badań wymienić należy:
- oznaczanie obecności patogenów alarmowych o mechanizmach oporności ESBL, VRE, CPE w wymazie z odbytu
- ocenę nosicielstwa Staphylococcus aureus w wymazie z nosa
- identyfikację patogenów górnych (angina) i dolnych dróg oddechowych, moczu, krwi, płynu mózgowo-rdzeniowego (pmr), płynów z jam ciała
- posiew wymazu z pochwy i odbytu w kierunku GBS (Streptococcus agalactiae)
- posiew wymazu z rany, zmiany skórnej, wydzieliny ropnej, ropnia
Ponadto Pracownia posiada dwa aparaty bazujące na metodach biologii molekularnej do szybkiej diagnostyki zakażeń (wynik nawet już po 50 minutach w zależności od rodzaju testu).
W aparacie BIOFIRE®FILMARRAY®2.0 odczynniki Multiplex PCR są zestawione w 5 panelach pozwalających na detekcję rożnych grup patogenów w zależności od jednostki chorobowej – np. zestaw do wykrywania patogenów jelitowych, patogenów dolnych i górnych dróg oddechowych, krwi i pmr.
Natomiast na aparacie GeneXpert IV możliwe są do wykonania oznaczenia obecności:
- wirusów: RSV, Grypy A i B oraz Sars-CoV-2 w jednym badaniu;
- bakterii Clostridioides difficile w próbie kału;
- 14 typów wirusa HPV wysokiego ryzyka w ramach jednej analizy. Test Xpert HPV w sposób swoisty identyfikuje typy HPV 16 i HPV 18/45 oraz zgłasza 11 innych typów wysokiego ryzyka (31, 33, 35, 39, 51, 52, 56, 58, 59, 66 i 68) w wyniku zbiorczym.
Personel:
| Kierownik Laboratorium | mgr Elżbieta Rakowska | |
| Z-ca Kierownika | mgr Anna Rafalont | |
| Diagności laboratoryjni | 14 osób | |
| Technicy analityki medycznej Sekretarki medyczne |
11 osób |
Informacje dla pacjentów:
- Cennik Badań laboratoryjnych - wrzesień 2025
- Instrukcja logowania do systemu wyników badań on-line
- Jak przygotowac się do badania krwi
- Jak przygotować się do badania moczu, kału
- Instrukcja pobrania moczu na posiew
- Zadbaj o serce
- Covid - profilaktyka
- SARS-CcV-2 - informacje
Dowiedz się więcej: